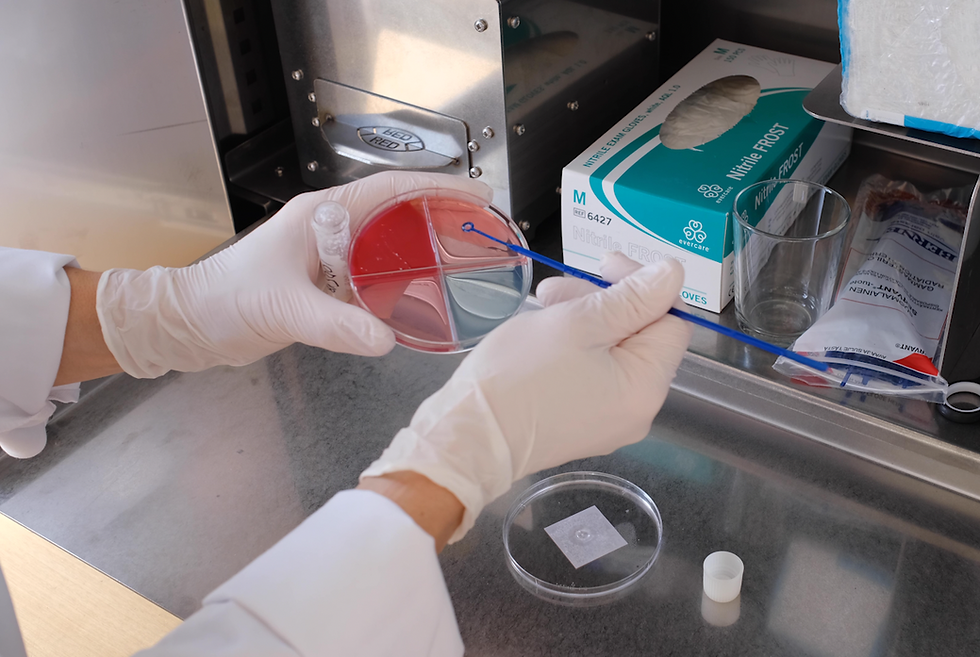

Eneberga Gård
– Så skapas en hållbar miljö för djur och personal
Eneberga Gård AB är ett familjeföretag som kombinerar traditionell kunskap med modern teknik för att driva en lönsam verksamhet inom mjölk- och köttproduktion samt växtodling. Gården är grundad av Bengt-Åke Johansson och vidareutvecklad av sönerna Tomas och Peter som idag har 250 mjölkande kor som mjölkas i 4 robotar och ett snitt ECM på 12 – 12 500.
Modern mjölkproduktion och ett sammansvetsat team
”Vi har under de senaste åren satsat på korna och vi är mycket måna om vår personal, att de trivs och att det finns en hållbarhet kring hela vår verksamhet – djur, natur och personal – allt ska vara i balans”, säger Tomas
Tomas fortsätter, ”Vi har en balanserad och lönsam verksamhet, men vi bedömer att det alltid finns mer att hämta hem. Via Agricam får dessutom vår besättningsveterinär tillgång till data som gör att vi genom samverkan kan få ytterligare en hävstång i vår utveckling”.

Marie Olofsson är förman på Eneberga sedan 2016. En av Enebergas styrkor ligger i deras engagerade personalstyrka. Förutom ägarna Tomas och Peter arbetar Marie tillsammans med Ellen Åhlén och Josefine Nilsson med att säkerställa djurens välbefinnande.
"Vi är ett väldigt sammansvetsat team! Alla har sina intressen och styrkor, vilket gör att vi kompletterar varandra mycket väl- jag brinner för fruktsamhet, Ellen har ett extra gott öga för och hand om kalvarna och Josefine är vass på klövar" säger Marie.
Förbättrad kommunikation och bibehållen djurhälsa med Agricam
Eneberga som har varit kunder sedan 2022 hade från början en god djurhälsa. En av huvudanledningarna att gården hoppade på tåget var för faktiskt bibehålla hälsoläget samtidigt som lösningarna skulle underlättade för kommunikationen mellan de olika arbetspassen
”I början var vi förväntansfulla till hur moderna digitala verktyg kunde bidra till att djuren mår ännu bättre, att produktionen ökar och inte minst att personalen skulle få tillgång till digitala appar som förenklar vardagen” säger Tomas.
”Innan Agricam så var det många lappar som skrevs och en hel del försvann. Vi skrev upp information på Whiteboards, men man glömde ibland bort att sudda ut och uppdatera information som lätt föll mellan stolarna” berättar Marie.
Så hur har det gått?
”Idag registreras allt i appen, vilket ger bättre överblick. Kommunikationen mellan arbetspassen har förenklats och förbättrats- samtidigt får vi tillgång till all historik för varje djur på ett smidigare sätt!” intygar Marie
Vilken hjälp har ni fått från Agricam?
”Som en av de första gårdarna som fick Agricam-appen har vi uppskattat att våra förslag och önskemål har blivit verklighet” säger Marie.
Gården har deltagit på produktutvecklingsmöten och uppskattar att det fanns en vilja att utveckla och ständigt lösningarna! De har omfamnat digitala lösningar för att förbättra djurhälsan och effektivisera arbetet. Genom Agricams appar och system har de fått nya möjligheter att arbeta datadrivet.
”Extra spännande var det att vara en del av utvecklingen av en ny klövhälsoapp”. Vi delar Agricams syn och filosofi att hållbarhet och hälsa går hand i hand med god lönsamhet”, säger Tomas.
Bacticam och ViLA
Eneberga har tidigare haft utmanande perioder med E.coli bakterier. Innan Bacticam så kallade gården ut en jourhavande veterinär som satte in penicillin och tog ett mjölkprov tillbaka till kliniken som odlades där. Om det visade sig att det var en E.coli så tvingades Eneberga att avbryta behandlingen.
”Det bästa med Bacticam är de snabba provsvaren, vilket gör att vi kan avvakta med behandlingen tills vi vet vilken bakterie som orsakat mastiten. Nu behandlar vi rätt djur”
Idag har gården i stället en dedikerad ViLA-veterinär som kommer ut varannan vecka till gården. Det är en stor skillnad att ha en engagerad veterinär som brinner för kor och som har god kännedom om gården. Tack vare snabba provsvar från Bacticam kan Eneberga nu behandla rätt djur i rätt tid.
Resultat som märks
Eneberga har upplevt konkreta förbättringar i djurhälsan:
- Antalet ketosfall har minskat. Med ketoskollen har Eneberga fångat upp korna som behöver extra energi så att det inte har resulterat i några större hälsostörningar trots ett lite sämre grovfoder. Överlag så upplever gården att färre kor "faller totalt," och de som hamnar i svackor kan oftare vändas. .
- E.coli-bekymmer har blivit färre med Bacticam vilket gör att antibiotikaanvändningen kan hållas låg.
Förutom bättre hälsa hos djuren har digitaliseringen även förenklat kommunikationen.
Vad krävs av användaren?
För att jobba digitalt så behöver man ge teknik, oavsett lösning, en ärlig chans menar Marie. Det är även upp till användaren att ställa frågor och hålla sig uppdaterade.
”Oftast när vi har en fråga eller ett önskemål så finns redan lösningen utvecklad i programmet, men man blir lätt hemmablind”
Håll dig uppdaterad via Nyhetsbrev och Kunskapsbanken med de olika instruktionsfilmerna. Uppföljningsmötena är givande där man går igenom gårdens statistik och nya produktuppdateringar - det är lärorikt och roligt berättar Marie.
Eneberga Gård är ett lysande exempel på hur svenska lantbrukare kan kombinera generationers erfarenhet med dagens teknologiska framsteg. Med ett starkt team, moderna verktyg och en tydlig vision fortsätter Eneberga att sätta djurens välbefinnande och hållbarhet i första rummet. Och inte minst- ha kul på jobbet!

”Djurens och personalens miljö ska vara hållbar. Därför känns det bra att vi nu får bra stöd som gör det enklare att fokusera på rätt aktiviteter. Inget ska riskera att falla mellan stolarna och vi bedömer att en bättre planerad vardag med möjlighet till snabb uppföljning, ska spara en hel del tid i vår verksamhet”, avslutar Tomas.
2024-12-05

Kontakta oss
Vill du veta mer? Fyll i formuläret så hör vi av oss!
